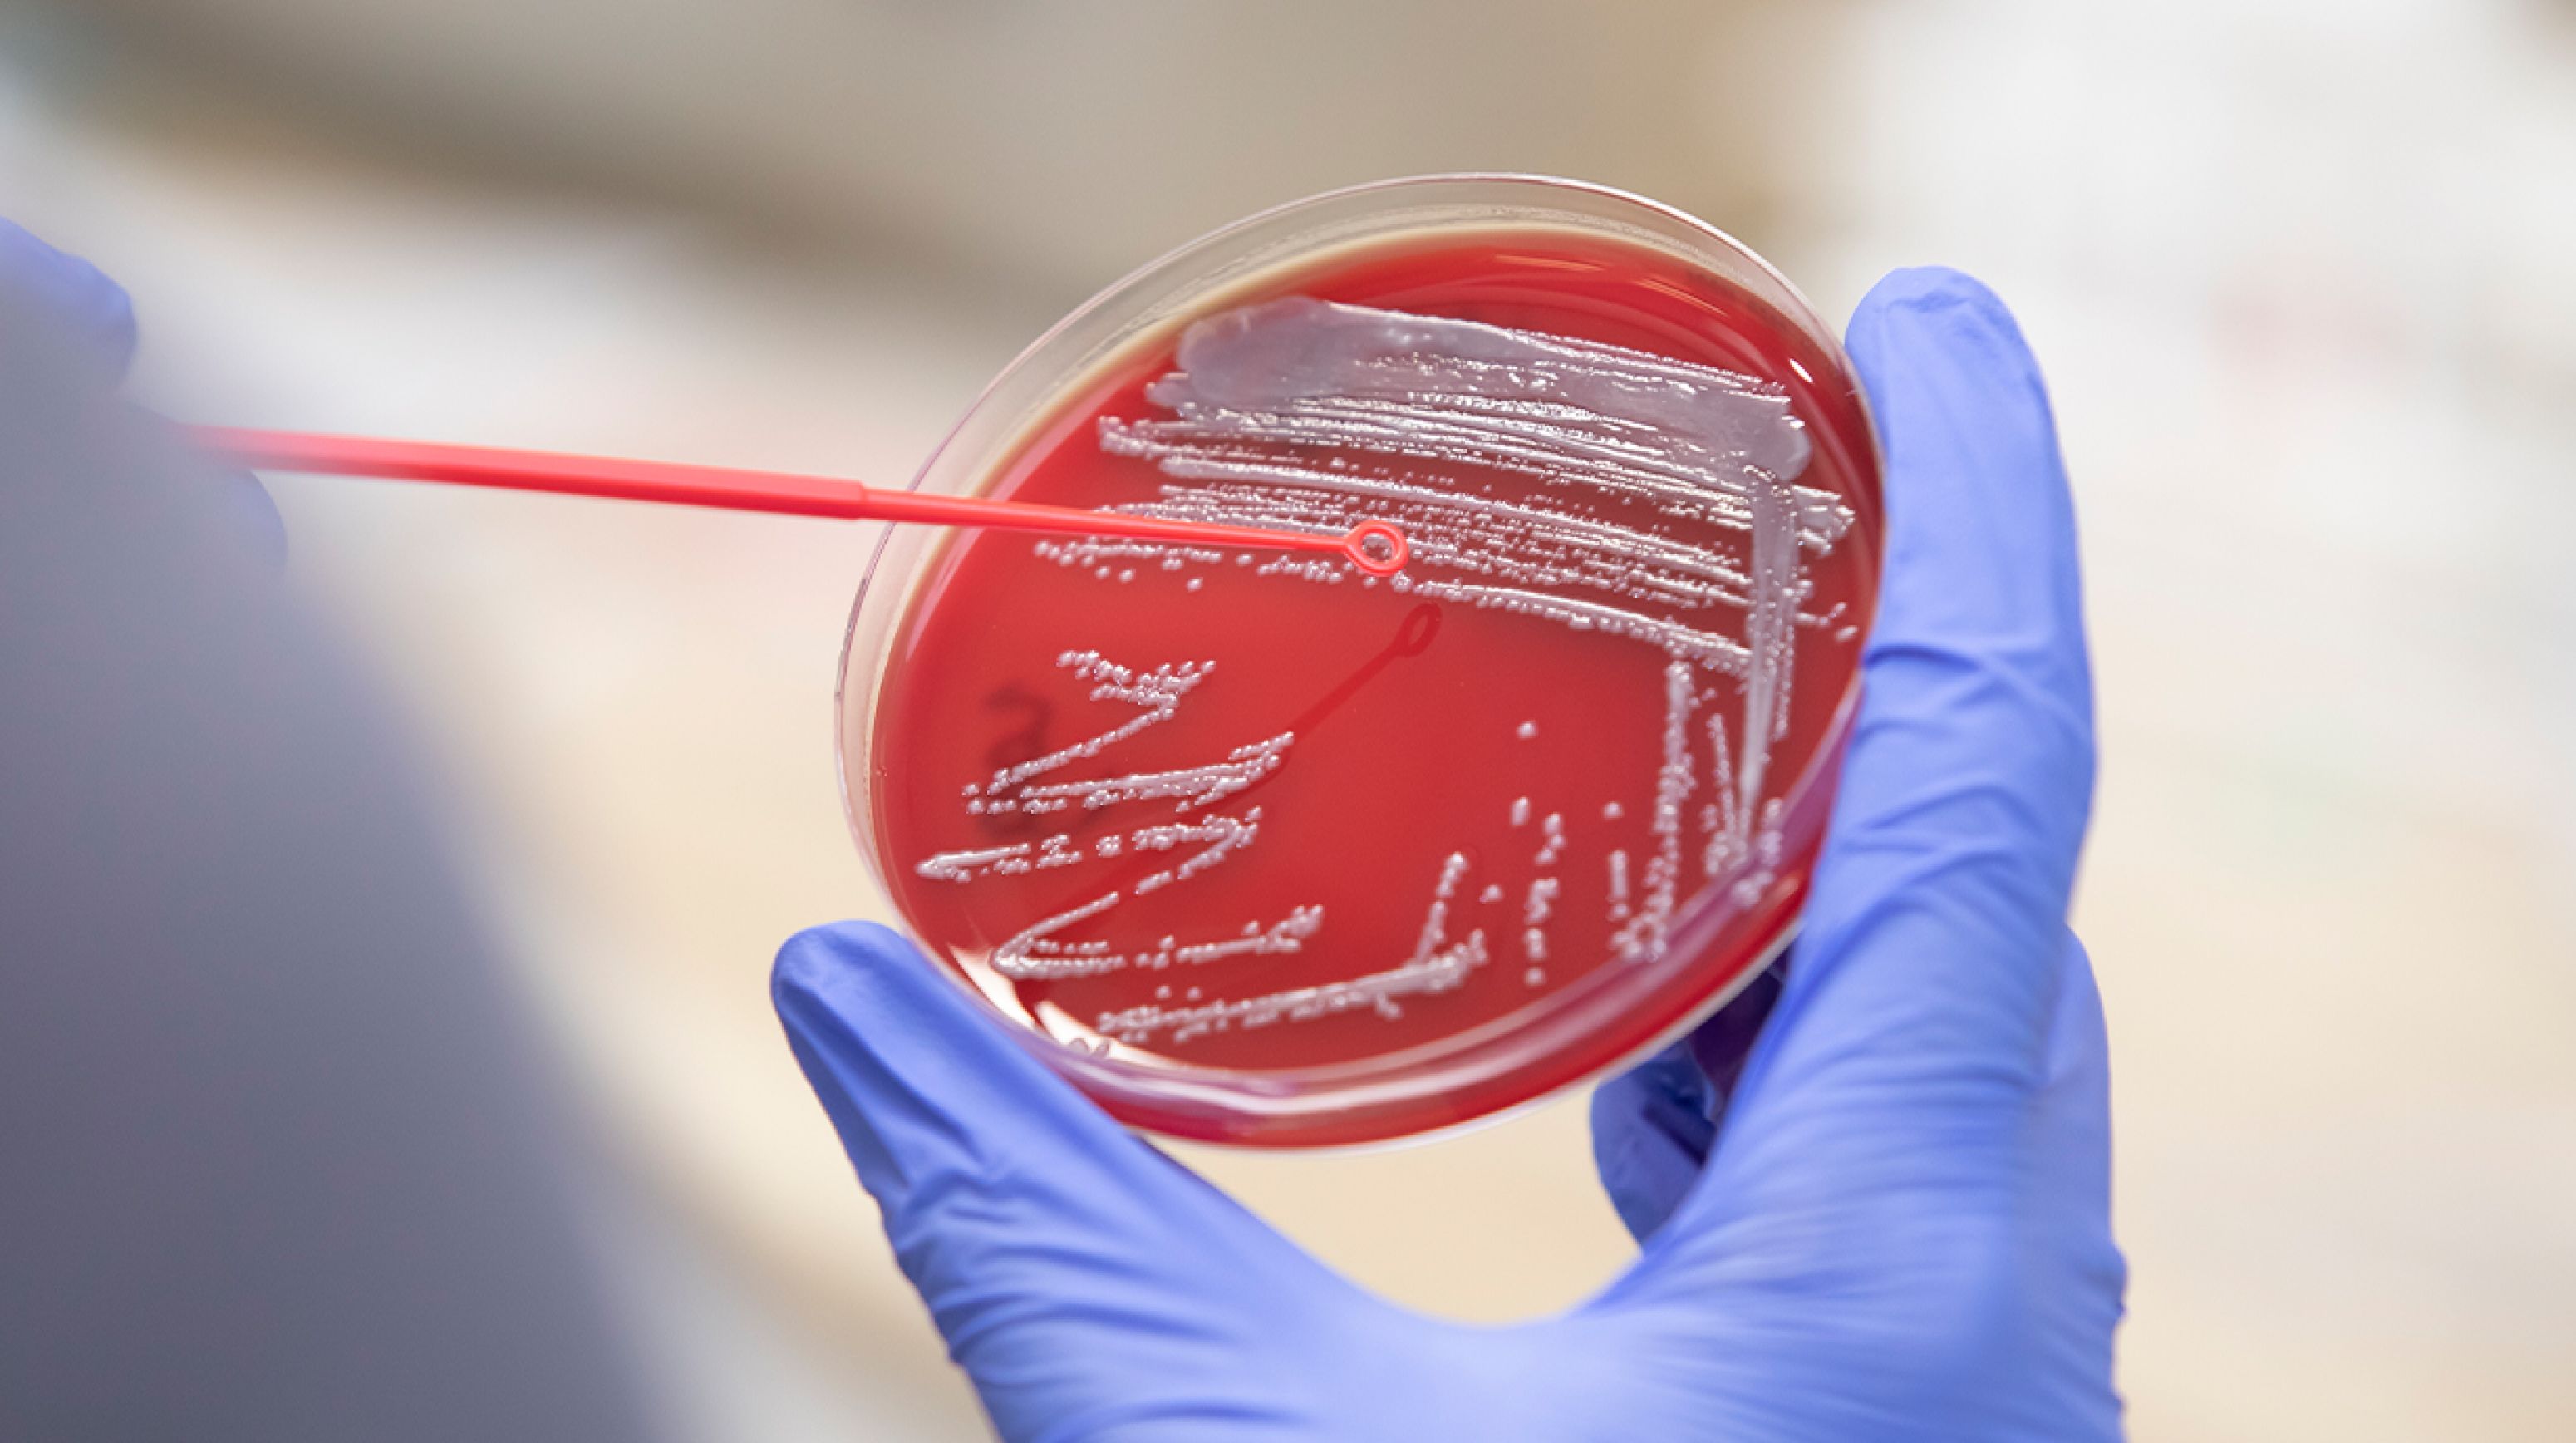

Ziekte onder uw koeien behandelen, maar bovenal voorkomen?
Of u nu melkvee-, vleesvee- of hobbyhouder bent, u wilt dat uw koeien gezond blijven. Daarom werken wij met geborgde rundveedierenartsen die IKM-gecertificeerd zijn. Zo staat er altijd iemand met ervaring bij u op de dam. Iemand die meedenkt over het behandelen, maar bovenal over het voorkomen van ziekte onder uw koeien.

Bel onze rundvee expert!
We zijn elke werkdag bereikbaar en bij spoed ook ’s avonds en in het weekend. Al onze dierenartsen zijn geborgde rundveedierenartsen. Er is dus altijd een deskundige rundveedierenarts beschikbaar.
Samenwerken aan vitaliteit
Heeft u een zieke koe, dan weten wij wat er moet gebeuren. We stellen een diagnose vast en starten op basis daarvan een behandeling. We schrijven bijvoorbeeld medicijnen voor of plannen een operatie. Dit doen we uiteraard in overleg. Ons doel is om problemen op te lossen, maar bovenal te voorkomen. Daarvoor bieden we bedrijfsbegeleiding: we beoordelen periodiek de gezondheid van uw koeien, bespreken de productiecijfers en nemen preventieve maatregelen. Zo werken we samen aan vitaliteit. Op alle fronten.
Gezichten van AnimalCare
Overzicht met een online portaal
Tussen de bedrijven door moet u een administratie bijhouden, onder meer over de gezondheid van uw koeien. Om u daarbij te ondersteunen, werken wij met een online portaal. Hier vindt u alle documenten, zodat u controleurs snel van de juiste informatie kunt voorzien. Bovendien loopt u nooit achter de feiten aan. U ontvangt een herinnering voor vaccinaties en het vernieuwen van de benodigde plannen.


De juiste vaccinatiestrategie
Vaccinaties vormen dé manier om ziektes, zoals longontsteking of kalverdiarree, van uw erf te houden. Een vaccinatie is pas echt betrouwbaar als u de juiste strategie kiest. Wilt u het hele koppel of een bepaalde groep beschermen? En gaat u voor toediening via een injectienaald of neusdruppel? Samen bepalen we wat er moet gebeuren en maken we een planning. Omdat wij elke donderdag een ‘vaccinatieronde’ doen, is er altijd een dierenarts beschikbaar.
Sterke klauwen
Hebben uw koeien sterke klauwen, dan draagt dit bij aan een goede voeropname, melkgift en vruchtbaarheid. Redenen genoeg dus om aandacht te besteden aan klauwverzorging. Wij zijn hierin gespecialiseerd. Zo verwijderen we tylomen en voeren we klauwamputaties uit. Ook doen we preventieve behandelingen om klauwen gezond te houden. Door samen te werken met collega experts kunnen we onze behandelingen steeds verder verbeteren.

Aanvullend onderzoek
Soms is er aanvullend onderzoek nodig om een diagnose vast te stellen. Zo kunnen we bij een koe met melkziekte bloed afnemen en op de praktijk direct het calciumgehalte in het bloed vaststellen. Verder doen we mestonderzoek bij kalverdiarree en worminfecties. En ook doen we zelf bacteriologisch onderzoek bij mastitis. Binnen twee dagen ontvangt u een behandeladvies en op basis van de uitslag kunnen we meedenken over maatregelen om problemen in de toekomst te voorkomen.

ONZE BEGELEIDING
Wij zijn graag de deskundige dierenarts achter elke melkveehouder. Werkt u met ons samen, dan bepaalt u zelf hoe vaak en wanneer u ons inschakelt. U kunt periodiek een afspraak plannen, een abonnement per koe afsluiten of gewoon contact opnemen als u ons nodig heeft. Belt u vanwege een spoedgeval? Dan staan wij binnen dertig minuten op uw erf.